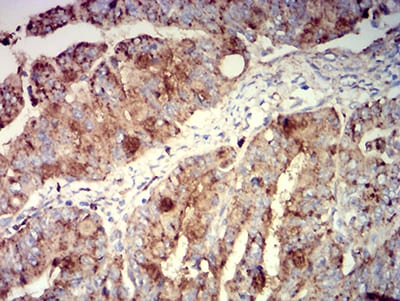

-
分类: 科研抗体货号: 31411别名: ITGAX; SLEB6应用: FCM反应种属: Human
-
分类: 科研抗体货号: 31396别名: FBP; FOLR应用: FCM反应种属: Human
-
分类: 科研抗体货号: 31410别名: APCL应用: IHC,IF,FCM反应种属: Human
-
分类: 科研抗体货号: 31425别名: p50; Bp50; CDW40; TNFRSF5应用: FCM反应种属: Human
-
分类: 科研抗体货号: 31419别名: R1; CD1; CD1A应用: FCM反应种属: Human
-
分类: 科研抗体货号: 31409别名: T3G; IMD17; CD3-GAMMA应用: WB,FCM反应种属: Human
-
分类: 科研抗体货号: 31424别名: MLA1; ME491; LAMP-3; OMA81H; TSPAN30应用: IHC,FCM反应种属: Human
-
分类: 科研抗体货号: 31418别名: R1; CD1; CD1A应用: FCM反应种属: Human
-
分类: 科研抗体货号: 31408别名: T3G; IMD17; CD3-GAMMA应用: FCM反应种属: Human
-
分类: 科研抗体货号: 31423别名: MLA1; ME491; LAMP-3; OMA81H; TSPAN30应用: IHC,FCM反应种属: Human

鄂公网安备42018502007531号
鄂公网安备42018502007531号

